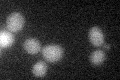
YIL023C
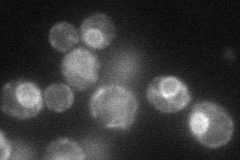
YIL023C
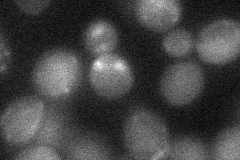
YIL023C
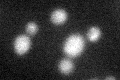
YIL023C

View description
Zinc transporter; localizes to the ER; null mutant is sensitive to calcofluor white, leads to zinc accumulation in cytosol; ortholog of the mouse KE4 and member of the ZIP (ZRT, IRT-like Protein) family
Localization:
Intensity:
Fold change:
Significance:
-
C’ GFP library in SD
below threshold16.22 -
N' NOP1pr-GFP in SD
ER57.1888 -
N' TEF2pr-mCherry in SD

ER57.0653 -
N' NATIVEpr-GFP in SD

below threshold13.5813 -
N' TEF2pr-VC and Cyto-VN in SD
below threshold23.8704 -
C’ GFP library in SD+DTT
cytosol16.030.98No -
C’ GFP library in SD+H2O2

cytosol16.691.02No -
C’ GFP library in Starvation Media

cytosol21.611.33No -
C’ GFP library on the background of Pup2-DaMP

below threshold -
C’ GFP library on the background of CCT mutant

below threshold16.43561.01311No
